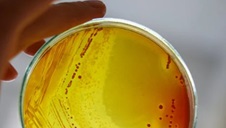

Past funding opportunities
The FHRI Fund releases funding programs in four cycles, opening in March, July and October and December each year. Subscribe for updates to be notified about upcoming funding cycles and other FHRI Fund announcements. Each funding cycle commences with an Open Day. Information about past open days.
Past Programs and Initiatives are listed below. For reference, versions of the Guidelines and Conditions and Application documents from the most recent Program round can be accessed from the relevant pages.
View the Funding Outcomes for past Programs and Initiatives.
![]() |
The 2021 Biobank Interim Support program provided bridging funds to high-quality WA biobanks to ensure they could transition to a new biobank model, once it was determined. |
![]() |
The Clinician Research Fellowships is a program of the Future Health Research and Innovation Fund and the Raine Medical Research Foundation, designed to encourage clinicians employed by WA Health Service Providers to develop their research capability while continuing some clinical duties. The program also facilitates high-quality research that will ultimately provide better health care outcomes. For further details visit the Clinician Research Fellowships page (external link). |
![]() |
The Clinician Researcher Training Program aimed to build the clinician researcher workforce in WA by providing scholarships for health professionals to undertake a Doctor of Philosophy (PhD) in a health and medical sciences area. |
![]() |
The 2024 Collaborative Centres program provided time-limited funding for WA researchers based in the WA public health system or private hospitals to substantially accelerate new or emerging programs of world-leading collaborative research and to develop and enhance national, and international partnerships. |
![]() |
The Co-Funding Partnerships Program (Co-FPP) established collaborations and funding partnerships to bring genuinely new non-government funding for health and medical research and innovation to WA, and aimed to build a culture that supported co-operation and interconnectedness.
For further details about the program, visit the Co-Funding Partnerships page. |
![]() |
The purpose of the DISCOV3R program aimed to investigate Rapid Antigen Tests (RATs) as a sustainable long-term testing solution for COVID-19. ‘3R’ refers to the three streams of the Program: Reassure; Reclaim; and Repurpose. |
![]() |
The Early Career Child Health Researcher (ECCHR) Fellowships program is a co-funded program of the Future Health Research and Innovation Fund and the BrightSpark Foundation, designed to encourage and support WA based early career researchers pursue a career in child health research. For more information and updates about the program visit the BrightSpark Foundation Website (external link) |
![]() |
The FHRI Fund Consumer and Community Involvement Support program aimed to support consumer and community involvement (CCI) in research and innovation activity. |
![]() |
The FHRI Fund Enabling Scheme 2023-24 aimed to increase the scale and excellence of health and medical research and innovation in WA by supporting accessible local infrastructure. |
![]() |
The FHRI Fund Enabling Scheme 2024-25 aimed to increase the scale and excellence of health and medical research and innovation in WA by supporting accessible local infrastructure. |
![]() |
The FHRI Fund Distinguished Fellows 2024-25 program aimed to attract outstanding research leaders to Western Australia, to build capacity and lead high quality, globally recognised research in WA. |
![]() |
The Implementation Science Fellowships 2020-21 program sought to identify strategies for the successful implementation of research findings into policy and practice in the WA public health system. |
![]() |
The Innovation Challenge 2021 - Child and Youth Mental Health 2020-21 program sought to stimulate innovation, and the development and delivery of a solution to a significant unmet need identified by the Challenge ‘winner’ in the area of child and youth (0 – 24 years) mental health in Western Australia. |
![]() |
The Innovation Challenge - Generative Artificial Intelligence Applications (Generative AI Challenge) sought creative solutions that use Generative Artificial Intelligence technology to address challenges in four streams. |
![]() |
The Innovation Challenge 2023 - Sustainable Health Priorities provided the opportunity for Western Australian innovators to propose innovative solutions in the six Sustainable Health Review (SHR) priority recommendations and two additional SHR areas (Sustainable Health Priority areas). |
![]() |
The Innovation Fellowships 2024 program sought to build human capability in health and medical related innovation and to increase the innovation capacity of Western Australia (WA). |
![]() |
The Innovation Fellowships 2024-25 program was designed to encourage talented Western Australians to enhance their innovation knowledge, skills and experience, in conjunction with experts who supervised and mentored them, while developing an innovation of significance to the health and/or wellbeing of the WA community. |
|
The Innovation Seed Fund provides the opportunity for WA innovators to develop and commercialise their innovation, create high-level health sector jobs and enhance the production/manufacturing capacity of the State. |
|
![]() |
The Innovative Solutions – Digital Health program aimed to build the capacity and capability of the WA innovation sector to leverage the potential of digital health technologies in improving health and/or wellbeing of the WA community. |
![]() |
The Innovative Solutions - Precision Health 2024 program supported the development and advancement of precision health innovations of significance to the health and or wellbeing of the WA community. |
![]() |
The Major Research and Innovation Application Support (MRIAS) program provides in-principle cash commitments for Western Australian grant applications being submitted to nationally or internationally competitive external grant funding programs, to boost their chance of success. |
![]() |
The Major Research Application Support (MRAS) program provides in-principle financial support for research applications being submitted to nationally and internationally competitive grant funding rounds to boost their chance of success. |
![]() |
The Medical and Health Research Infrastructure Fund (MHRIF) aimed to promote excellence in medical and health research in Western Australia by providing funding support for the indirect costs of research. The 2021 round was funded by the Future Health Research and Innovation (FHRI) Fund. |
![]() |
The National Collaborative Research Infrastructure Strategy (NCRIS) Partner Program 2024-25 aimed to leverage Australian Government and partner funding for the collaborative acquisition of national research infrastructure to maintain and grow WA’s cutting-edge health and medical research and innovation capabilities |
![]() |
The Research Excellence Awards (REA) program aimed to recognise and support WA’s most outstanding researchers by providing discretionary funding that could be applied strategically to research opportunities. |
![]() |
The Research and Innovation Capacity and Capability Building Program (RICCBP) 2024-25 aimed to enhance Western Australia’s health and medical research and innovation capacity and capability through initiatives that developed workforce skills, built knowledge, fostered collaboration and increased national and international competitiveness. |
![]() |
The Research Infrastructure Support (RIS) 2024program aimed to provide a sustainable health and medical research environment and to promote excellence in health and medical research in Western Australia. |
![]() |
The Research Infrastructure Support (RIS) 2025program aimed to provide a sustainable health and medical research environment and to promote excellence in health and medical research in Western Australia |
![]() |
The 2021 Research Translation Projects (RTP) program supported high-quality research projects that had the potential to identify efficiencies and cost savings, which could be translated into policy and/or practice in the WA public health system, while maintaining or improving patient outcomes. |
![]() |
The Targeted Call - Health System Solutions program 2023-24 aimed to facilitate the development and implementation of innovative solutions to Business Challenges to address unmet health and medical needs or opportunities identified by WA Health Service Providers (HSPs). |
![]() |
The Translation Fellowships Program 2021-22 aimed to support translational research in the area of mental health. |
![]() |
The Western Australia (WA) Cohort Studies-Operational Support Program (WACS-OSP) 2022-23 provides a source of operational funding to eligible cohort studies that is awarded based on demonstrable competitive excellence and use. |
![]() |
The Western Australia (WA) Cohort Studies-Operational Support Program (WACS-OSP) 2024-25 provided a source of operational funding to eligible cohort studies based on demonstrable competitive excellence and use. |
![]() |
The Western Australia (WA) Cohort Studies-Research Support Program (WACS-RSP) 2022-23 was designed to fund population health research projects, including appropriate interventional studies. |
![]() |
The WA Near-Miss Awards Emerging Leaders 2025-26 program targeted researchers who narrowly missed out on securing a National Health and Medical Research Council (NHMRC) Investigator Grant, which is considered a critical career milestone for researchers. |
![]() |
The WA Near-Miss Awards Ideas Grants 2023-24 program provided funding to eligible early and mid-career researchers to enhance areas of their NHMRC Ideas Grants 2023 application that were identified through the NHMRC peer review process as being improvable. |
![]() |
The WA Near-Miss Awards Ideas Grants 2024-25 program provided funding to eligible early and mid-career researchers to enhance areas of their NHMRC Ideas Grants 2023 application that were identified through the NHMRC peer review process as being improvable. |